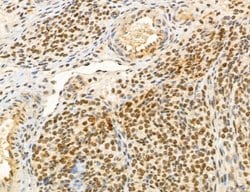
Invitrogen MACC1 Polyclonal Antibody 100 &mu;L; Unconjugated:Antibodies,

missing translation for 'onlineSavingsMsg'
Learn More
Learn More
Invitrogen™ MACC1 Polyclonal Antibody


Rabbit Polyclonal Antibody
Brand: Invitrogen™ PA5115530
This item is not returnable.
View return policy
Description
Antibody detects endogenous levels of total MACC1.
MACC1 (Metastasis associated in colon cancer 1) is a key regulator of the hepatocyte growth factor (HGF)-HGF receptor (MET) pathway, which is involved in cellular growth, epithelial-mesenchymal transition, angiogenesis, cell motility, invasiveness, and metastasis. MACC1 protein consists of four domains: ZU5, SH3, and two C-terminal death domains (DD). Expression of MACC1 was found significantly upregulated in malignant tissues (colon cancer of all stages as well as liver and lung metastases) compared to normal tissues or adenomas. MACC1 represents an early and crucial prognostic indicator for colon cancer metastasis that is independent of age, sex, tumor infiltration, nodal status, and lymph vessel invasion. Besides its involvement in signal transduction with the MET receptor, MACC1 also links MET signaling and apoptosis. MACC1 may also be an important therapeutic target for colorectal cancer treatment. At least two isoforms of MACC1 are known to exist.
Specifications
| MACC1 | |
| Polyclonal | |
| Unconjugated | |
| MACC1 | |
| 4732474O15Rik; 7A5; Gm267; MACC1; metastasis associated in colon cancer 1; metastasis-associated in colon cancer protein 1; putative binding protein 7a5; RGD1309838; SH3 domain-containing protein 7a5; SH3BP4L | |
| Rabbit | |
| Affinity Chromatography | |
| RUO | |
| 238455, 314539, 346389 | |
| -20°C | |
| Liquid |
| Immunohistochemistry (Paraffin), Western Blot | |
| 1 mg/mL | |
| PBS with 50% glycerol and 0.02% sodium azide | |
| Q6ZN28 | |
| MACC1 | |
| A synthesized peptide derived from human MACC1(Accession Q6ZN28), corresponding to amino acid residues N86-R136. | |
| 100 μL | |
| Primary | |
| Human, Mouse, Rat | |
| Antibody | |
| IgG |
Product Content Correction
Your input is important to us. Please complete this form to provide feedback related to the content on this product.
Product Title
Spot an opportunity for improvement?Share a Content Correction